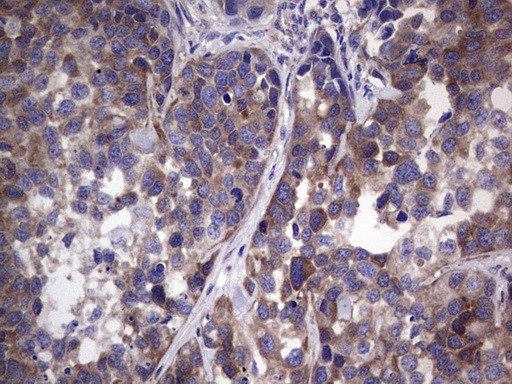
GARS Antibody in Immunohistochemistry (Paraffin) (IHC (P))

Search
OriGene
GARS Monoclonal Antibody (OTI4H8), TrueMAB™
{{$productOrderCtrl.translations['antibody.pdp.commerceCard.promotion.promotions']}}
{{$productOrderCtrl.translations['antibody.pdp.commerceCard.promotion.viewpromo']}}
{{$productOrderCtrl.translations['antibody.pdp.commerceCard.promotion.promocode']}}: {{promo.promoCode}} {{promo.promoTitle}} {{promo.promoDescription}}. {{$productOrderCtrl.translations['antibody.pdp.commerceCard.promotion.learnmore']}}
产品信息
TA805076
种属反应
宿主/亚型
分类
类型
克隆号
抗原
偶联物
形式
浓度
规格
纯化类型
保存液
内含物
保存条件
运输条件
靶标信息
GARS is a glycyl-tRNA synthetase, one of the aminoacyl-tRNA synthetases that charge tRNAs with their cognate amino acids. This protein is an (alpha)2 dimer which belongs to the class II family of tRNA synthetases. The protein has been shown to be a target of autoantibodies in the human autoimmune diseases, polymyositis or dermatomyositis.
仅用于科研。不用于诊断过程。未经明确授权不得转售。
篇参考文献 (0)
生物信息学
蛋白别名: 6.1.1.14; AIR synthase; AIRS; AP-4-A synthetase; Ap4A synthetase; Charcot-Marie-Tooth neuropathy 2D; Charcot-Marie-Tooth neuropathy, neuronal type, D; Diadenosine tetraphosphate synthetase; EC 2.1.2.29; GAR transformylase; GART; GARTF; Glycine--tRNA ligase; Glycyl-tRNA synthetase; Glycyl-tRNA synthetase 1; GlyRS; MGC47764; PAIS; PGFT; PRGS; unnamed protein product
基因别名: CMT2D; DSMAV; GARS; GARS1; GlyRS; HMN5; HMN5A; HMND5; SMAD1; SMAJI
UniProt ID: (Human) P41250
Entrez Gene ID: (Human) 2617